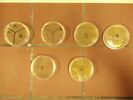

Wettbewerbe - Naturwissenschaften

Schüler*innen aller Klassen- und Jahrgangsstufen werden zur Teilnahme an den vielfältigen Wettbewerben in den Fächern Biologie, Chemie und Physik angehalten und, wo erforderlich, begleitet.
Interessierten Schüler*innen wird die Teilnahme an den vier Experimentalwettbewerben bio-logisch, Chem-pions, Dechemax und IJSO (JuniorScienceOlympiade) empfohlen. Diese lassen sich grob auf die unterschiedlichen Jahrgangsstufen aufteilen:
bio-logisch: 5-10
Chem-pions: Klasse 5-8
IJSO: bis 16 Jahre (im Klassenverband auch älter)
Dechemax: ab Klasse 7 (empfohlen ab Klasse 9)
Bei allen Wettbewerben stehen das Experiment und seine Auswertung im Vordergrund. An einem der vier Wettbewerbe nehmen alle Schüler*innen in Bio-Chemie gemeinsam teil, diese Teilnahme ersetzt eine schriftliche Überprüfung.
Darüber hinaus können die Schüler*innen zusätzlich an Jugend forscht, RACI, freestyle physics, der ChemieOlympiade (IChO) bzw. der PhysikOlympiade (IPhO) und am Wettbewerb "Chemie - die stimmt" teilnehmen.
Zusätzlich haben die Schüler*innen haben die Möglichkeit in der Sekundarstufe I im Klassenverband am Projekt der AOK „Be smart don’t start“ teilzunehmen.
Zu den Wettbewerben
- Biologie
- Chemie
- Physik
Be smart don't start
Der Klassenwettbewerb "Be Smart – Don’t Start" eignet sich hervorragend, um weitere Aktivitäten zum Thema Nichtrauchen und Gesundheitsförderung durchzuführen. Der Kreativität sind dabei keine Grenzen gesetzt: Es können Projekttage durchgeführt werden, Videos, Songs oder Gedichte zum Nichtrauchen erstellt werden,
Verantwortliche in Politik, Medien und Gesellschaft angeschrieben und auf das Thema aufmerksam gemacht werden usw.
Durch die Teilnahme bei Be Smart soll Schüler*innen ein Anreiz gegeben werden, gar nicht erst mit dem Rauchen anzufangen. Er richtet sich daher besonders an die Klassen (6-8), in denen noch nicht geraucht wird oder nur wenige Schüler*innen rauchen. Rauchfrei sein heißt übrigens: Die Klasse sagt "Nein“ zu Zigaretten, E-Zigaretten, Shishas, E-Shishas, Tabak und Nikotin in jeder Form.
Als Hauptpreis des Wettbewerbs wird eine Klassenreise vergeben.
Ansprechpartner*innen: alle Biologielehrer*innen
bio-logisch
bio-logisch! ist ein Einzelwettbewerb für Schüler*innen, die über den Unterricht hinaus an biologischen Fragestellungen und Phänomenen interessiert sind. Die Neugierde und die Motivation zum Forschen soll unterstützt und gefördert werden. Der Wettbewerb findet einmal jährlich von Frühjahr bis zu den Sommerferien statt. Auf die Jahrgangsbesten wartetet eine Einladung zu einer viertägigen Schülerakademie. Besonders erfolgreiche Schüler*innen werden zu einer Feierstunde eingeladen. Dabei werden Buch- und Sachpreise sowie Urkunden vergeben. In jedem Bezirk werden darüber hinaus engagierte Schüler*innen zu einem regionalen Aktionstag eingeladen. Alle Teilnehmer*innen erhalten eine persönliche Urkunde. Am Leibniz kann dieser Wettbewerb in das Differenzierungsfach Biochemie integriert sein und eine schriftliche Leistung ersetzen.
Ansprechpartner*innen: alle Biologielehrer*innen
Bundesumweltwettbewerb
Du interessierst dich für Umweltschutz/nachhaltige Entwicklung und arbeitest dazu an einem spannenden Projekt? Du bist zwischen 10 und 20 Jahre alt? Dann bist du hier genau richtig! Gehe Umweltproblemen auf den Grund und löse sie nachhaltig mit Kreativität und Engagement unter dem BUW-Motto „Vom Wissen zum nachhaltigen Handeln“.… Der BUW ist der einzige Projektwettbewerb der sechs ScienceOlympiaden. Seit der Gründung im Jahr 1990 nehmen am Wettbewerb jährlich immer mehr an Themen zu Umwelt und nachhaltiger Entwicklung interessierte und tatkräftige Jugendliche und junge Erwachsene teil. Mit ihren Projekten leisten sie ihren Beitrag dazu, Wissen in nachhaltiges Handeln umzusetzen.
Ansprechpartner*innen: alle Biologiefachkräfte
Chemie-die stimmt!
"Chemie - die stimmt"! bietet Schüler*innen der Klasse 8 bis 10 einen Einstieg in die faszinierende Welt der Chemie. Zu Beginn eines Schuljahres lädt die erste Runde mit altersgerechten, an den Lehrplan angepassten Aufgabenstellungen zum Knobeln, Recherchieren und Experimentieren ein. Bereits auf der zweiten Ebene, den Landesrunden, können die Teilnehmenden andere naturwissenschaftliche Interessierte treffen und einen Einblick in aktuelle Themen der Chemie erhalten. Die bundesweite Finalrunde findet in Leipzig statt. Durch Experimentalvorträge an Universitäten, Exkursionen zu industriellen Anlagen, sowie reichlichen Kontakt zu Studierenden und Forschenenden, können viele Teilnehmende Chemie für sich entdecken. Zum Schluss bildet dieser Wettbewerb das ideale Sprungbrett zur Internationalenen ChemieOlympiade.
Ansprechpartner*innen: alle Chemielehrkäfte
Erfolge 2019: Chemie die stimmt & ChemieOlympiade & RACI
Chem-pions
Chem-pions ist ein Experimentalwettbewerb, der die Experimentierfähigkeit der Schüler*innen weckt. Am Leibniz werden Experimentiernachmittage zu den Chem-pions Experimenten gemeinsam mit Chemielehrkräften durchgeführt. Inhaltlich steht jeweils ein Alltagsprodukt oder Alltagsphänomen im Mittelpunkt, zu dem chemische Experimente durchzuführen sind und protokolliert werden müssen. Dieses Protokoll muss dann von den Schüler*innen digital erstellt und auf der Chem-pions Homepage selbstständi hochgeladen und abgeschickt werden. Am Leibniz kann dieser Wettbewerb in das Differenzierungsfach Biochemie integriert sein und eine schriftliche Leistung ersetzen.
Ansprechpartner*innen: alle Chemielehrkräfte
DECHEMAX
DECHEMAX ist eine Initiative der DECHEMA (Gesellschaft für Chemische Technik und Biotechnologie e.V., die aus der Deutschen Gesellschaft für chemisches Apparatewesen hervorging). DECHEMAX weckt bei Jugendlichen Begeisterung fpr Naturwissenschaften und Technik und wagt es, die Dinge auch anders, lebendig, aktuell und praxisnah zu erklären, als das in der Schule manchmal der Fall ist.
Der Gruppenwettbewerb, in dem 3-5 Schüler*innen ab Klasse 7 gemeinsam teilnehmen, ist in der ersten Runde online als Multiple-Choice-Test zu lösen. Nachdem sie 6 von 8 Fragen richtig beantwortet haben, erreichen sie die zweite experimentelle Runde. Hier wird (häufig in der Schule) geforscht und ein Bericht geschrieben.
Ansprechpartner*innen: alle Chemielehrkräfte
IJSO
Der Auswahlwettbewerb zur Internationalen JuniorScienceOlympiade (IJSO) ist die jüngste der sechs ScienceOlympiaden am IPN an der Universität Kiel, die vom Bundesministerium für Bildung und Forschung sowie den Kultusbehörden der Länder gefördert werden.
Wer sich ganz allgemein für Naturwissenschaften und nicht nur speziell für eine Fachdisziplin interessiert, ist hier genau richtig.
An der ersten Runde kann sich jeder - auch zusammen mit Freunden - ohne große Einstiegshürde beteiligen: Die Aufgaben bestehen aus einfach durchzuführenden Experimenten, an die sich weiterführende Fragen knüpfen.
Am Leibniz kann dieser Wettbewerb in das Differenzierungsfach Biochemie integriert sein und eine schriftliche Leistung ersetzen.
Ansprechpartner*innen: alle Chemielehrkräfte
IChO
Die Internationale Chemie-Olympiade (IChO) ist ein Wettbewerb, in dem Schüler*innen ihre Leistungen bei der Bearbeitung theoretischer und experimenteller Aufgaben aus dem Bereich der Chemie miteinander messen. Dieser Wettbewerb findet jährlich in den Sommermonaten statt. Die Schüler*innen erhalten in der ersten Runde Aufgaben, die sie zu Hause lösen und zur Korrektur an ihren Chemielehrer*innen abgeben. Dieser sendet die Lösungen ein. Bei über 50 % richtig bearbeiteten Aufgaben erreichen die Schüler*innen die 2. Runde, in der sie eine Klausur lösen müssen.
Hier geht es zu den Aufgaben.
Seit 2017 nehmen interessierte Schüler*innen des Leibniz-Gymnasiums am Vorbereitungsseminar zur Olympiade teil, wo Grundlagen wiederholt und notwendige Kenntnisse zur Bearbeitung besprochen werden, da nicht alle Kenntnisse im Unterricht vermittelt werden.
Ansprechpartnerin: Frau Winkelmann
Erfolge 2019: Chemie die stimmt & ChemieOlympiade & RACI
Vorbereitungsseminar zu IChO an der Uni Essen (2018-1)
Vorbereitungsseminar zur IChO an der Uni Essen (2018-2)
Erfolge bei der Olympiade (2018-1)
Erfolge bei der Olympiade (2018-2)
RACI
Seit 2018 nehmen unsere Q1-Chemie-Schüler*innen am Multiple-Choice-Test RACI teil, zu dem die Lehrkräfte jedes Jahr höchstens 20 ausgesuchte Schüler*innen anmelden dürfen, der Wettbewerb wird von MINT-EC organisiert.
Ansprechpartner*innen: alle Chemielehrkräfte
IPhO
Dann bist du hier genau richtig! Die Internationale PhysikOlympiade - kurz IPhO - ist ein Wettbewerb für physikbegeisterte Schüler*innen aus aller Welt, die einmal im Jahr bei theoretischen und experimentellen Aufgaben ihre Leistungen messen und um Medaillen kämpfen.
Ansprechpartnerin: Frau Gronenberg
Hier geht es zu den Aufgaben.
Freestyle physics
Jedes Jahr kurz vor den Sommerferien findet an der Universität Duisburg-Essen das riesige Physik-Ereignis "freestyle physics" statt. Am Leibniz bereiten jeweils in den Sommermonaten Schüler*innen aller Jahrgangsstufen ihre Beiträge zum Wettbewerb vor.
Ansprechpartnerin: Frau Gronenberg
vom Wettbewerb zur besonderen Lernleistung
In unserem Bundesland ist es möglich, einen Wettbewerbserfolg als besondere Lernleistung in der Schule anerkennen zu lassen. Ein Erfolg kann somit in die Zeugnisnote berücksichtigt werden. Es bietet sich an, mit den eigenen Lehrer*innen einmal darüber zu sprechen, ob die Anerkennung als besondere Lernleistung möglich ist.
Informationen zur besonderen Lernleistung (5. Abiturfach) sind unter Oberstufe zu finden!
Würdigung exzellenter Facharbeiten
Warum sollen beispielsweise Facharbeiten im Schularchiv oder zu Hause im Bücherregal oder „in der Schublade“ schlummern? Beim BUW und beim icbf hat man die Chance, das eigene Werk von Experten einer Fachjury beurteilen zu lassen, wertvolle Preise zu gewinnen und die Arbeit einer breiteren Öffentlichkeit zu präsentieren. Es lohnt sich, die eigene Facharbeit einzureichen.
Um beim BUW erfolgreich zu sein, muss die Facharbeit den Wettbewerbsbedingungen entsprechen, d.h. die formalen Kriterien sind einzuhalten. Diese sind dem BUW-Leitfaden zu entnehmen. Entsprechend dem BUW-Motto “Vom Wissen zum nachhaltigen Handeln” sollten bei der Betrachtung eines Problems zu Umwelt/Nachhaltigkeit die entwickelten Lösungsvorschläge möglichst in konkretes Handeln umgesetzt werden. Facharbeiten sollten daher gegebenenfalls um diese Handlungskomponente ergänzt werden.
http://www.buw.uni-kiel.de/der-wettbewerb/fuer-projektmitglieder
Beim icbf können Facharbeiten eingereicht werden, wenn sie aus den Fächern Biologie, Chemie, Geographie, Mathematik oder Physik stammen.